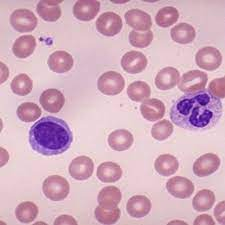

Iron Deficiency Anemia.
PKGhatak, MD
Anemia is defined by the WHO as having less than 12 gm /dL of hemoglobin in women and less than 13gm /dL in men. By this criterion, 33 % of the world's population has anemia and half of the cases are due to iron deficiency. Children below 5 years old and women of childbearing age are particularly susceptible to iron deficiency anemia in sub-Saharan Africa and South Asia. Iron deficiency anemia is the number one nutritional disorder in the world.
Iron deficiency anemia develops when the iron store is depleted and the daily loss of iron exceeds the daily iron intake. The consequences of iron deficiency anemia are many, chief among them are dysfunctions of several systems of the body, and notably among them are limitation of physical work, reduced energy production, depressed immune function, recurrent infection, poor digestive function, and various neurocognitive functions. The diagram below is an outline of iron utilization.
Iron containing proteins in humans.
Four general categories of proteins contain iron: (1) heme proteins (e.g., hemoglobin. (2) mononuclear iron proteins (e.g., superoxide dismutase), (3) diiron-carboxylate proteins (e.g., ribonucleotide reductase, ferritin), (4) iron-sulfur proteins (e.g., aconitase), Hemoglobin is the most abundant iron-containing protein in humans. More than one-half of total-body iron is contained within hemoglobin.
Basic physiology of Iron in humans.
Iron is a very reactive metal and combines readily with oxygen, when it reacts with H2O2 (hydrogen peroxide) it generates oxygen radicals. Oxygen radical sickens living cells and in the end, kills cells. To protect tissue from its harmful effects, a protein, ferritin, combines with iron. Moving in and out of cells requires conversion of ferric to ferrous state and must pass special areas of the cell membrane called gates. Once inside the cells, iron is converted back to ferric state and in the blood and inside the cells iron remains combined with ferritin.
The generation of RBC is called erythropoiesis. Demand for erythropoiesis comes from: (a)Tissue oxygenation, (b)Erythrocyte turnover, (c) Blood loss from hemorrhage.
(a)Tissue oxygenation remains more or less stable in health.
(b) Approximately 20 mL of old erythrocytes die daily, and 20 mg of iron is recovered from the dead RBC. The immediate source of iron for erythroblasts is mono or diferric transferrin, found in high concentrations in plasma. The sources of diferric transferrin are the gut (diet), macrophages (recycled iron), and the liver (stored ferritin iron). the diet.
2.5mL of whole blood contains 1.0 mg of iron. 1.0 mg of iron is absorbed from the diet daily and 20 mg of iron from recycled erythrocytes is available to support erythropoiesis. Once iron stores are depleted, dietary and recycled erythrocyte iron is not usually sufficient to compensate for acute blood loss. In a normal person, less than 2 mL of blood is lost daily in the stool. But this tiny amount of blood in stool does not give a positive occult blood test. A minimum of 60 mL/d is needed for a positive occult blood test to detect the presence of blood in the stool. Women in childbearing age lose additional blood due to menstruation. Repeated nosebleeds and regular blood donation lower body stores of iron.
Iron in pregnancy:
It is estimated that about 1.2 gm of iron is required from conception through delivery. The breakdown is as follows: (i)Mother's erythrocyte mass should increase from 350 to 450 mL. And that needs 450mg of iron (ii) Cessation of menstruation saves 600 mg of iron (iii) A full tern newborn has 280 mg (iv) Placental loss 90 mg.
At birth, the fetal red cell mass is 50 mL/kg. (Compared with 25–30 mL/kg in adults). Even in anemic mothers, the fetal ferritin levels remain 10 times higher than the maternal ferritin, indicating nature's preferential treatment of a growing child over the mother.
Common causes of iron deficiency in poor countries.
1. Poor diet. Red meat, organ meat and egg are good sources of iron. Poor people can hardly provide meat or eggs on a regular basis. Bush meat in Africa, at one time adequately supplied the local population, but increased demand by the growing urban population has dried up this source. Vitamin C improves iron absorption, but tea and coffee interfere with absorption. Inorganic iron absorption requires multiple mechanisms, but infections and inflammation depress iron absorption by hepcidin inhibitory action.
2. Malaria. Malaria is a special circumstance. Intravascular hemolysis from the effects of parasites and Blackwater fever produces severe anemia. In addition, malnutrition depresses iron absorption.
3. Hookworm. It is an intestinal parasite, that is a significant source of GI blood loss in millions of people in South Asia and Africa. Defecation in the open, and walking in bare feet in flooded fields make it possible for hookworms to enter the body. Each worm takes 0.3 to 0.5 mL of blood from the upper small intestine and produces anemia. [ see footnote ]
4. Gastrointestinal factors. Suppressed gastric acid secretion from taking a proton pump inhibitor or gastric mucosal atrophy from gastritis, prevents the release of iron from organic iron in food. Tropical sprue and other duodenal pathologies hinder iron absorption from the gut. Liver diseases may decrease ferritin production and in chronic infection, excess hepcidin decreases GI iron absorption. And finally, Helicobacter infection of the stomach produces gastritis and causes decreased iron absorption.
A look at the peripheral blood in iron deficiency anemia.
Blood of a normal person.
The characteristic features of iron deficiency anemia are
The RBCs are microcytosis (small sized cells) and hypochromic (pale). In addition, a combination of increased red cell distribution width (RDW), decreased red blood cell (RBC) count, decreased MCH (mean corpuscular hemoglobin), and decreased mean cell volume are manifested. Red cells are pale in the center, smaller in size and the shape is variable and easily identifiable on blood smears. Because of non-steady state hemopoiesis, the RDW shows wider variation and is usually over 15%. This is marked in contrast with the Sickle cell trait. The red cells in the sickle cell trait are also small and pale in the center and the hemogram appears similar to iron deficiency but RDW remains in the normal range due to the fact that hemopoiesis is steady because the iron stores in the body are full and so also the of serum iron and ferritin saturation index. In iron deficiency, the serum ferritin level is 15 μg/L or below. In research centers, the iron concentration of the reticulocytes, erythroblasts, the bone marrow and the liver is determined, but in clinical practice, those tests are not needed for diagnosis. Iron deficiency causes increased release of soluble transferrin (transport protein) from erythroblasts. Therefore, ratios of soluble transferrin receptor and ferritin are used to detect iron-deficient erythropoiesis.
Treatment of iron deficiency anemia,
Replacement of the iron stores is the first priority. Oral iron preparations are of two kinds. Inorganic and inorganic iron. Inorganic iron preparations are affordable but difficult for patients to tolerate because they produce constipation, nausea and anorexia. Organic iron preparations are easier to tolerate but expensive. In previous generations, intravenous iron therapy was problematic because of frequent hypersensitive reactions. The improved formulation has made rapid correction of anemia possible.
Advances in Iron knowledge.
The most significant advance is the discovery of hepcidin. Hepcidin expression is highly variable and influenced by a circadian rhythm. That knowledge should improve dosing regimens. When iron therapy does not improve iron deficiency anemia, TMPRESS6 gene mutation is suspected. In normal conditions, the TMPRESS6 gene provides instructions for the Matriptase-2 protein molecule, which is a part of the controlling mechanism of hepcidin production in the liver.
________________________________________________________________________________________
Footnote:
1. Larva entering by piercing skin of feet---> enter venous blood and carried to the right heat chambers, then to pulmonary capillaries----> larva moving out from lung alveoli to airways and crawls up the trachea----> coughed up and swallowed----> enters the stomach and settles in upper small intestine---- sucks blood, matures, mates, releases eggs----> egg containing feces deposited in open fields and the cycles continue.
********************************************************************